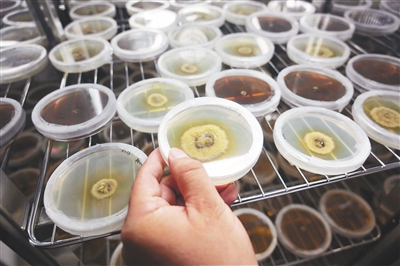

海南种业系列深度报道之二 农业微生物
■ 本报记者 傅人意
内容点击
蘑菇,是人们对大型真菌的口语化称呼。
7月5日,海南医学院药学院实验室,今年43岁的“蘑菇教授”曾念开坐在小板凳上认真指导一旁的研究助理宇文江,让他边观察显微镜下的白牛肝菌,边用铅笔勾画它的显微结构。
做科研还要会画画?这是曾念开在进行大型真菌种质资源搜集和保存过程中严格要求研究组工作人员和学生必备的技能。因为菌类和植物类不同,只有手绘才能将其“孢子”“锁状联合”这一重要结构精准记录,为下一步的物种鉴定打下基础。
近年来,在海南,无论是在高校还是在科研院所,都有一群专注于大型真菌种质资源保护的力量在聚集。从搜集、保存到利用,海南特色菌种正不断探路前行。
日前,省农业农村厅印发《海南省农业种质资源保护和利用发展规划(2021-2025年)》,将作物、畜禽、水产、农业微生物四大类纳入种质资源保护和利用的重点任务。作为海南农业微生物重要组成部分,在国家打响种业翻身仗的大背景下,大型真菌种质资源保护和利用的现状如何?它们在乡村振兴产业发展上又将扮演怎样的角色?海南日报记者对此进行了走访。
A
“90后”蘑菇团队的故事背后
我省建立大型真菌种质资源库,收集特色珍稀食药用菌80多种
7月5日,炎炎午后,海南日报记者走进海南医学院真菌标本馆,一股清凉扑面而来。
牛肝菌、鹅膏、灵芝……记者拉开标本柜的抽屉发现,每一个标本都有自己的编号。别看只有几十平方米,这里却“住着”千奇百怪的菌类家族:目前收藏了近万个真菌标本,是中国热带地区规模较大的真菌标本馆。为了更好地保存标本,标本馆湿度常年保持在30%左右,空调低温设置在20℃。
“近日,海南医学院真菌标本馆载入国际标本馆索引,并获得国际标本馆代码FHMU。”曾念开介绍,“标本馆建于2012年,既是自然历史档案馆,也具有类似图书馆的功能,可以在种质资源保护利用上起到关键作用。”
然而,制作这些标本的菌种,采集起来却并不容易。它们“行踪”神秘,还时常躲在林中和人们“捉迷藏”,并且生长周期有限。
所以,曾念开带领的团队——菌物资源与可持续利用研究组经常在雨后“巡山”搜集菌类。该团队共12人,除了4位老师,其他成员平均年龄为26岁,所以也被称为“90后”蘑菇团队,他们的足迹已遍布全省18个市县。
早上6点,天刚蒙蒙亮,“90后”蘑菇团队就爬到了山上,“早去早回”是他们的行动准则。“一天的采集量要控制在20朵以内,只采集精品,否则后期整理资源时会耗费不必要的精力。”曾念开说,在山上发现蘑菇后,要第一时间拍照记录,拍摄时他们有一个标准动作——对蘑菇行“跪拜大自然”之礼:整个人趴在湿漉漉的泥地上,双手举着相机,对焦,按下快门。
有时山特别陡峭,需要手脚并用,才能顺利上山。山里还会有很多蚂蟥、蚊虫,条件险恶。“但是我们现在都习惯了。有时由于太专注,也没发现被蚂蟥叮咬。”曾念开笑着说。
采集到蘑菇后,要第一时间赶回住处,测量菌盖、菌柄、菌管、菌孔的相关数据,解剖菌肉,观察变色情况,烘干保存……
为何如此赶时间?“因为蘑菇是一种‘善变’的微生物,比如牛肝菌就具有变色特征,5分钟内,它会变红、变蓝、变黑,而相机是无法准确记录这个过程的,这就需要我们快速用笔记下,为日后的种质资源鉴定提供依据。”曾念开说,大型菌类种质资源搜集和保护工作由不得半点马虎。
随后,在“巡山”的当天晚上,研究组成员要将采集的蘑菇进行烘烤,次日早上将烘干的标本放到自封袋,回到实验室后,再将标本在零下20℃的冰柜冷冻2周,之后装进牛皮纸袋,最后进行编号、收藏保存。
这支“90后”蘑菇团队的故事,正是我省收集和保护大型真菌种质资源工作的一个缩影。
省农业农村厅相关负责人介绍,近年来,依托国家科技支撑计划、公益性行业(农业)科研专项、南锋专项二期等项目,海南省建立了农业微生物菌种库和大型真菌种质资源库,不同生境微生物的分离、鉴定及保存技术不断完善,先后收集了有海南特色、经济价值高的珍稀食药用菌80多种,共分离保存菌种约2万份。
同时,我省还成功开发了黑皮鸡枞菌等特色高值食用菌,研发了复合微生物菌肥、灵芝孢子粉等微生物产品,有力支撑了绿色农业和健康食品产业发展。
B
从实验室到海南特色菌产业
唤醒“沉睡”的菌种,按下海南特色菌产业发展“加速键”
在位于海口的中国热带农业科学院热带生态农业科技馆里,顶着小云朵般菌盖的灵芝已经展开,在阳光的照耀下,闪着漆样的光泽。
据相关资料显示,我国拥有丰富的灵芝种类资源,而海南又是中国灵芝科真菌分布最多的地区。目前世界上发现的野生灵芝有200多种,我国已知的有103种,其中分布在海南的有70多种,占世界的35%左右。
“灵芝实现人工栽培,一方面可满足市场需求,另一方面可挽救野生资源。”中国热带农业科学院环境与植物保护研究所(以下简称环植所)食用菌专家徐林介绍,目前环植所收藏有100多份大型真菌活体资源,标本200多份。在大型真菌种质资源收集过程中,他们还在海南中部山区发现弯柄灵芝、虎乳灵芝等有海南特色、经济价值高的珍稀食药用菌。
在实验室里,这些“沉睡”的菌种一旦被唤醒,就会按下海南特色菌产业发展的“加速键”。
“我们的产品已经实现电商销售,在淘宝、京东、有赞等平台都很受欢迎。”儋州牧春绿色生态农业开发有限公司总经理林才伟表示,灵芝最适合种植的温度是28℃,相比北方,海南一年四季均可种植,夏季通过设施降温的方式即可满足种植条件。此外,海南野生灵芝物种丰富,种质资源多样,这种特色资源成为海南发展热带特色高效农业的最大优势。
不仅是灵芝,一些食用菌也在呈产业化发展趋势。在定安龙湖南科食用菌有限公司1000多亩的食用菌栽培基地里,公司生产种植的秀珍菇、猪肚菇、黑皮鸡枞菌等食用菌,年产值超4000万元。
该公司办公室主任莫煌贤介绍,近年来,公司和中国热带农业科学院合作共建食用菌生产基地,食用菌品种经过科学驯化,培育出耐热性强的菌种,有利于种植和推广。去年,基地又增建了260亩“农光互补-光伏食用菌”大棚,总投资1.1亿元,将光伏电站和食用菌大棚建设合二为一,建设现代高效农业综合经济体。
“总体来说,海南特色菌类利用和发展起步比较晚,大概在2015年才出现一些规模以上企业。”曾念开观察到,目前贵州“黔菌”、云南“滇菌”都已形成食用菌产业,有力带动了当地农户增收。“相比而言,海南菌类产业规模小而散,仍然有很大的挖掘空间和广阔的发展前景。”曾念开说。
C
更多特色资源
有待挖掘和利用
亟需有关部门进行有效引导,
破解产业政策壁垒
一位业内人士透露,海南菌类资源开发利用慢,最主要的原因是早期种质资源保护搜集工作力量薄弱,不少种植户只能从省外购买种质资源,种植后出现水土不服。可见,种质资源搜集、鉴定、保存的“摸家底”工作至关重要。
徐林在深入调研的过程中还发现,不少当地农民在对待特色菌类上存在两种情况:一种是没有认识到这些菌类的宝贵价值,另一种是过度采摘,造成资源浪费与破坏。
他举例,比如海南特色药用真菌资源——虎乳灵芝,有利于治疗呼吸道疾病,但我省资源分布地的居民却对它知之甚少。与此相反,虎乳灵芝在马来西亚却广为人知,且已研发相关制品并上市销售。“目前海南的一些药店,也有销售虎乳灵芝,说明有市场需求。这就亟需有关部门进行有效引导,实现‘在保护中开发,在开发中保护’。另外,我们团队目前正在针对虎乳灵芝做人工栽培实验,成功后有望小范围试点推广。”徐林说。
一些产业政策上的壁垒也亟待破题。海南热带农业与农村经济研究院院长柯佑鹏举例,十年前海南灵芝产业曾遇到过发展契机,但是由于行业没有出台相关标准规范,使消费者对灵芝的一些功效不明,品种混淆不清,整体呈现无序发展状态。并且当时灵芝还受制于产业政策壁垒,没有纳入食药同源目录。
此外,有种植户认为,食用菌以林下种植为主,想要扩大规模,就需要新建一批生产大棚,但是目前林地不能进行设施农用地备案,大大制约了产业发展。
值得注意的是,去年初,国家卫健委、国家市场监督管理总局发布了《对于党参等9种物质开展按照传统既是食品又是中药材的物质管理试点工作的通知》,灵芝被纳入其中。
“海南可以申请列入试点,有助于产业壮大发展。”柯佑鹏表示,目前《中华人民共和国海南自由贸易港法》已经出台,赋予了海南更大的立法权和改革自主权,未来建议在行业规范、政策扶持等方面,给予海南特色真菌资源更多支持。
此外,海南有约2000万亩经济林,食用菌可以结合海南“三棵树”(橡胶树、槟榔树、椰子树)共同发展,助力脱贫攻坚和乡村振兴的有效衔接。
源源不断的科研力量,也在助推海南特色菌类产业迈步向前。在曾念开的实验室里,摆放着不同的“盆栽”:橡胶树、椰子树、槟榔、芒果树、荔枝树等。“这是我们目前对黑牛肝菌开展规模化种植树木的林下仿野生栽培试验,如果成功,将有望为海南乡村振兴提供有力支撑。”曾念开坚信,未来,会有越来越多的海南特色菌类,从种业源头冒出尖尖角,乘着海南自贸港建设的东风,为海南打赢种业翻身仗提供强大助力。(本报海口7月7日讯)